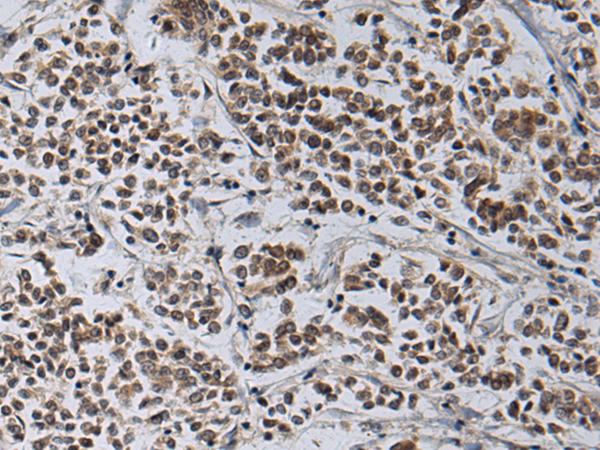
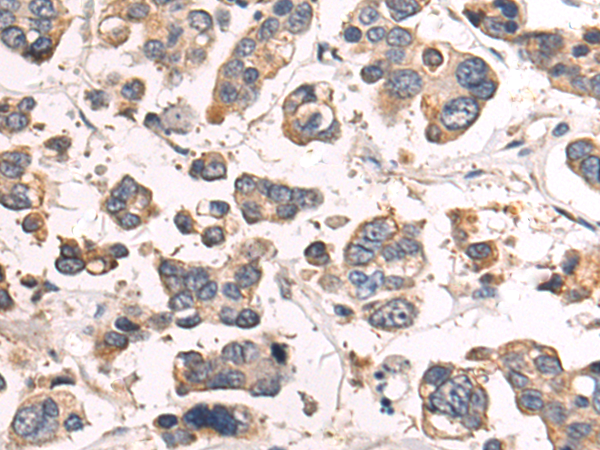

-
分类: 科研抗体货号: P10412别名:应用: IHC反应种属: Human, Mouse
-
分类: 科研抗体货号: P10411别名: FINCA应用: IHC反应种属: Human
-
分类: 科研抗体货号: P10427别名: L19; QSK; SEMDK; SIK-3应用: IHC反应种属: Human, Mouse
-
分类: 科研抗体货号: P10410别名: PIX2; SOFT; WDR51A应用: WB,IHC反应种属: Human, Mouse
-
分类: 科研抗体货号: P10444别名: BCS; BJS; PTD; BCS1; FLNMS; h-BCS; MC3DN1; h-BCS1; GRACILE; Hs.6719应用: IHC反应种属: Human, Mouse
-
分类: 科研抗体货号: P10425别名: ZNT3应用: WB,IHC反应种属: Human, Mouse, Rat
-
分类: 科研抗体货号: P10409别名: LARK; RBM4A; ZCRB3A; ZCCHC21应用: WB反应种属: Human, Mouse
-
分类: 科研抗体货号: P10443别名: RNB6应用: WB,IHC反应种属: Human, Mouse, Rat
-
分类: 科研抗体货号: P10424别名: TLL; TLX; XTLL应用: WB,IHC反应种属: Human, Mouse
-
分类: 科研抗体货号: P10408别名: HR23A; HHR23A应用: WB反应种属: Human, Mouse

鄂公网安备42018502007531号
鄂公网安备42018502007531号

